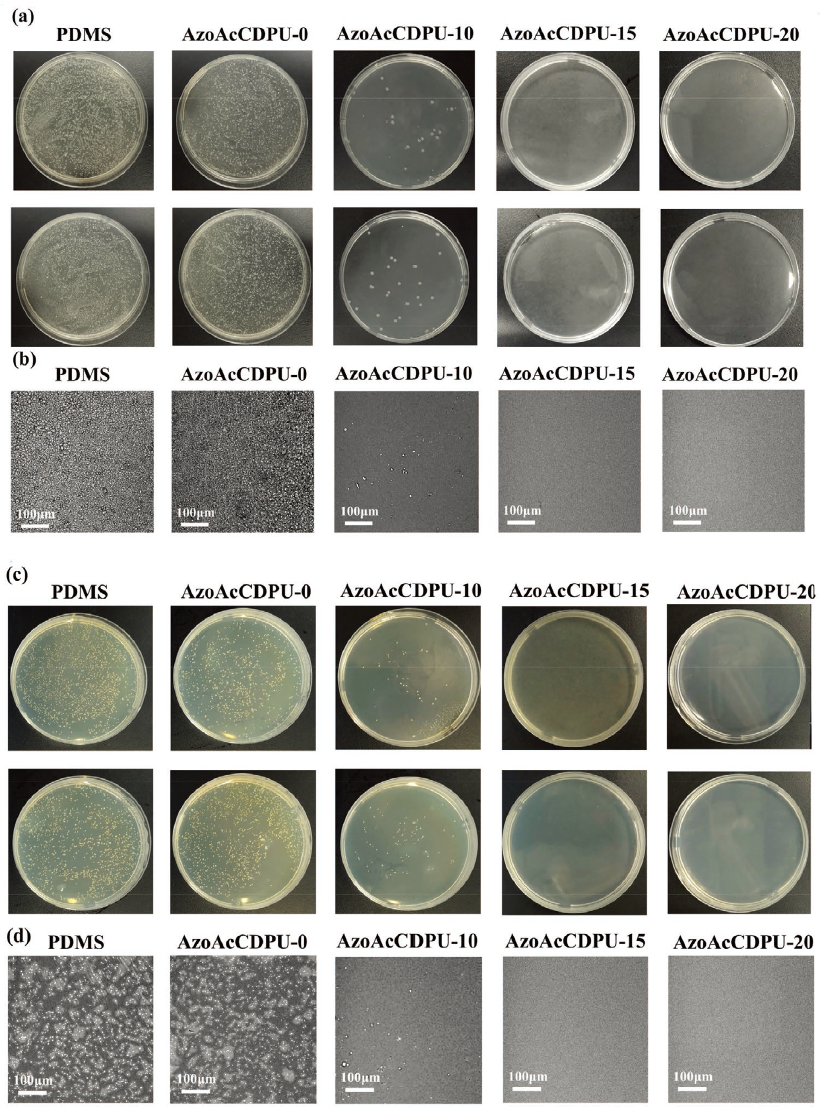
PDMS和防污涂料抵抗大肠杆菌粘附的性能

4224
2022-04-08
颗粒在线讯:生物污染对人类活动的方方面面都产生了严重的负面影响,尤其是对人类海洋事务的影响尤为严重。防污涂料是解决海洋生物污染最有效、最可行的手段之一。光滑注液多孔表面(slippery liquid-infused porous surface, SLIPS) 在防污领域得到了广泛的关注,但其表面润滑的可控性和润滑剂的耐久性相对不足,一直是亟需解决的问题。

近日,浙江大学张庆华教授、詹晓力教授课题组受盲鳗分泌粘液以躲避捕食者的防御行为启发,制备了一种具有响应式切换润滑模式和自修复特性的智能SLIPS海洋防污涂层。引入偶氮苯(Azo)与α-环糊精(α-CD)之间的响应性超分子相互作用来调节SLIPS的润滑。在可见光或加热条件下,顺式Azo通过超分子相互作用转化为反式并与α-CD结合,驱动聚合物链的收缩,将储存的润滑剂挤压到表面。响应式润滑油的自我补充可调节表面润滑性,智能切换“增强”与“正常”防污模式,适应不同场合。此外,引入二硫键和氢键能够有效提高自愈性能(91.73%)。综上所述,它具有高效的自清洁、抗蛋白、抗菌、抗藻等特性,在繁荣季节具有180天的真实海洋防污性能(是报告的SLIPS材料在真实海洋现场测试中最长的防污期),在浅海设备及其他防污领域具有广阔的应用前景。相关工作以“Hagfish-inspired Smart SLIPS Marine Antifouling Coating Based on Supramolecular: Lubrication Modes Responsively Switching and Self-healing Properties”为题发表在最新一期的《Advanced Functional Materials》。

方案1. 基于盲鳗启发的SLIPS海洋防污涂料的设计与响应机制。
当被捕食者刺激时(机械刺激、光刺激等),盲鳗会立即分泌粘液,减少摩擦,帮助盲鳗快速逃脱。在此,受盲鳗防御行为的启发,基于α-CD和Azo之间的超分子相互作用,研究者制备了一种具有响应切换润滑模式和自修复性能的智能滑移防污涂层(方案1)。

方案2. SLIPS海洋防污涂料的合成工艺,a) AzoPU和b) AcCDPU。
【防污涂料的合成工艺】
Azo改性有机硅PU (AzoPU)和乙酰化α-CD (AcCD)改性有机硅PU (AcCDPU)的合成工艺如方案2所示。“AzoAcCDPU”是涂层的聚合物基体,它是由AzoPU和AcCDPU按一定比例均匀混合而成。然后以不同质量分数加入硅油,命名为“AzoAcCDPU-x”(x为硅油质量分数:x%)。通过UV-vis光谱表征证明了涂层中的Azo在可见光或加热下响应,由反式转化为顺式,并与AcCD发生超分子相互作用。

图1. AzoAcCDPU-15的EDS图谱,a)可见光处理前,b)可见光处理后;c) AzoAcCDPU-15表面可见光处理前后的XPS。
【表面元素的表征】
通过对涂层响应前后表面元素的表征,验证了涂层的润滑响应渗流性能。能量色散X射线能谱仪(EDS)和X射线光电子能谱仪(XPS)的测试结果证实了硅油在AzoAcCDPU-15表面在可见光响应下的渗漏。如图1a所示,N和S在可见光处理后从表面元素的映射中消失。在图1b的XPS中,响应后,表面N和S的峰值消失,说明表面被硅油润滑层覆盖。

图2. AzoAcCDPU-10/15/20可见光处理前(a)和处理后(c)的扫描电镜(SEM);AzoAcCDPU-10/15/20的AFM (b)可见光处理前和(d)可见光处理后。
【表面形貌表征】
通过对反应前后涂层表面形貌的表征,证明了涂层的润滑剂响应性渗漏。如图2所示,在无响应的表面上有许多微孔。在固化过程中,由于搅拌过程中形成的微气泡逸出,基体呈微空腔分布结构。此外,微孔结构增强了毛细管作用,增强了润滑剂的贮存能力。硅油响应渗透后,表面微腔结构大部分被填充,表面被润滑层覆盖。随着硅油添加量的增加,这种自我补充性能增强。SEM照片显示,AzoACCDPU-15和AzoAcCDPU-20表面光滑,几乎没有微腔结构。

图3. a) WCA和b)不同处理(黑暗或可见光; 50°C高温或RT)下AzoAcCDPU-15液滴滑动性能;c)不同处理条件下AzoAcCDPU-15(滑块尺寸:25.4 mm × 76.2 mm)液滴滑动性能
【表面润滑和润湿性的响应切换性能】
润滑剂在表面的响应性渗漏也会改变表面润滑性能,引起宏观性能(WCA和液滴滑动性能)的变化。如图3所示,经过可见光/加热处理后,涂层表面水滴的滑动速度明显增加,WCA降低。由于硅油在表面的响应性渗透,使得表面有更多的润滑层,减少了与涂层基体的摩擦,增加了液滴的滑动速度。从宏观上看,WCA从104.5°降低到95.3°,液滴滑移速度从32.9 mm s-1增加到77.1 mm s-1,证明了在可见光/加热后,渗流润滑剂降低了粗糙度,提高了润滑性能。
此外,还进行了一些对比实验,证明这一反应过程是由Azo&AcCD在可见光/加热刺激下的超分子相互作用引起的。如图3c所示,涂层在可见光或加热后液滴滑动速度有所提高,而在黑暗和未加热条件下,液滴滑动速度没有明显变化。这些对比实验表明,可见光/加热对涂层的刺激作用是诱导硅油渗透的必要条件。

图4. 不同粘度硅油对AzoAcCDPU-15的稳定性:a) pH, b)盐度,c)离心,d)动态冲洗(200转/分); AzoAcCDPU-15通过e)可见光f) 50°C热的润滑油响应循环自我补充性能。
【稳定性和循环性能】
影响滑移涂料应用的最重要原因之一是稳定性不足。y轴上的“v (mm s-1)”表示水滴在一定倾斜角(30°)下在涂层上滑动的速度。涂层基体和润滑剂的主体为PDMS。由于PDMS具有优良的化学惰性,涂层表面的润滑性不受物品海水(ASW)的pH(0-14)和盐度(0-7 wt.%)的影响,如图4a,b。抗外部机械作用(离心和冲洗)的稳定性如图4c,d所示。由于硅油与PDMS基基质的适当相容性,以及微腔与基质中储存的润滑剂之间的毛细管力,润滑剂与基质之间的稳定性显著增强。循环响应的性能如图4e,f所示。在至少10个“抽汲-响应”循环中,涂层在去除表面润滑层后可以重复响应,证明了涂层响应性能的可重复性。

图5. a) UV (350 nm)、加热(50℃)固化PU的数码照片;b)修复涂层的修补效率(RE)和杨氏模量;c) AzoAcCDPU-0/10/15/20在350 nm UV下愈合过程的数码照片。

图6. AzoAcCDPU-15 (载片尺寸:25.4 mm × 76.2 mm)对a)固体模型污染物和b)液体模型污染物的自清洁性能;c)荧光显微镜照片和d)吸光度-浓度定量测试涂层的抗蛋白(BSA)粘附性能。
图7. PDMS和防污涂料抵抗大肠杆菌粘附的性能:a) LB板(直径9 cm)法;b) SEM观察;PDMS和防污涂料抵抗金黄色葡萄球菌粘附的性能:c) LB板法d) SEM观察。
【小结】
综上所述,本研究制备了基于盲鳗启发的超分子滑移体作为海洋防污涂料。由于偶氮和α-CD之间的响应性超分子相互作用,该智能涂层可以调节表面润滑性,在“增强”和“正常”防污模式之间切换,能够适应不同的防污需求,优化耐久性。与传统的低SE防污涂料相比,该智能SLIPS保持了高效的自修复效果和响应性防污性能,提高了在繁荣季节180天的实际浅海应用性能。该研究为设计“智能”防污涂料提供了有效的策略,有望在海洋、医疗、生物等领域得到应用。
版权与免责声明:
(1) 凡本网注明"来源:颗粒在线"的所有作品,版权均属于颗粒在线,未经本网授权不得转载、摘编或利用其它方式使用上述作品。已获本网授权的作品,应在授权范围内使用,并注明"来源:颗粒在线"。违反上述声明者,本网将追究相关法律责任。
(2)本网凡注明"来源:xxx(非颗粒在线)"的作品,均转载自其它媒体,转载目的在于传递更多信息,并不代表本网赞同其观点和对其真实性负责,且不承担此类作品侵权行为的直接责任及连带责任。其他媒体、网站或个人从本网下载使用,必须保留本网注明的"稿件来源",并自负版权等法律责任。
(3)如涉及作品内容、版权等问题,请在作品发表之日起一周内与本网联系,否则视为放弃相关权利。